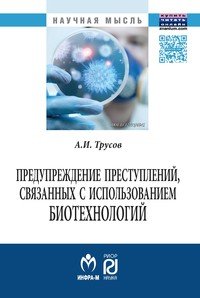

18+
На сайте представлено только описание и выходные данные книги «Предупреждение преступлений, связанных с использованием биотехнологий А. И. Трусов». Сайт не является распространителем книги. Сайт не предоставляет возможности купить, читать онлайн или скачать бесплатно книгу «Предупреждение преступлений, связанных с использованием биотехнологий А. И. Трусов». Сайт предназначен для лиц старше 18 лет. Если вам не исполнилось 18 лет - незамедлительно покиньте сайт. Оставаясь на сайте вы подтвердаете, что вам исполнилось 18 лет.
Незаконное потребление наркотических средств, психотропных веществ, их аналогов причиняет вред здоровью, их незаконный оборот запрещен и влечет установленную законодательством ответственность
Биотехнологическая революция предоставила широкие возможности гуманистического использования результатов открытий. Однако в среднесрочной перспективе следует ожидать появления совершенно новых для России преступлений, связанных с нелегальным использованием современных биотехнологий. Монография рассчитана на курсантов, студентов, адъюнктов, аспирантов, соискателей, занимающихся исследованиями в данных областях. Также может быть использована преподавателями и научными сотрудниками вузов. Это и многое другое вы найдете в книге Предупреждение преступлений, связанных с использованием биотехнологий (А. И. Трусов)
| Полное название книги | А. И. Трусов Предупреждение преступлений, связанных с использованием биотехнологий |
| Тип | Книга |
| Автор | А. И. Трусов |
| Категории | Уголовное право. Уголовный процесс., Книги, Юридическая литература |
| ISBN | 9785369014202 |
| Возрастное ограничение | 18 |
| Издательство | РИОР |
| Год | 2015 |
| Название транслитом | preduprezhdenie-prestupleniy-svyazannyh-s-ispolzovaniem-biotehnologiy-a-i-trusov |
| Просмотров | 4 |
| Рейтинг izbe.ru | 0,0 |

Мари Мур

Брук Лин

Конкордия Антарова

Дэниел Киз

Абрахам Вергезе

Аида Синицына

Вадим Зеланд

Сергей Лукьяненко

Роберт Грин

Виктор Дашкевич

Роман Прокофьев

Пауло Коэльо